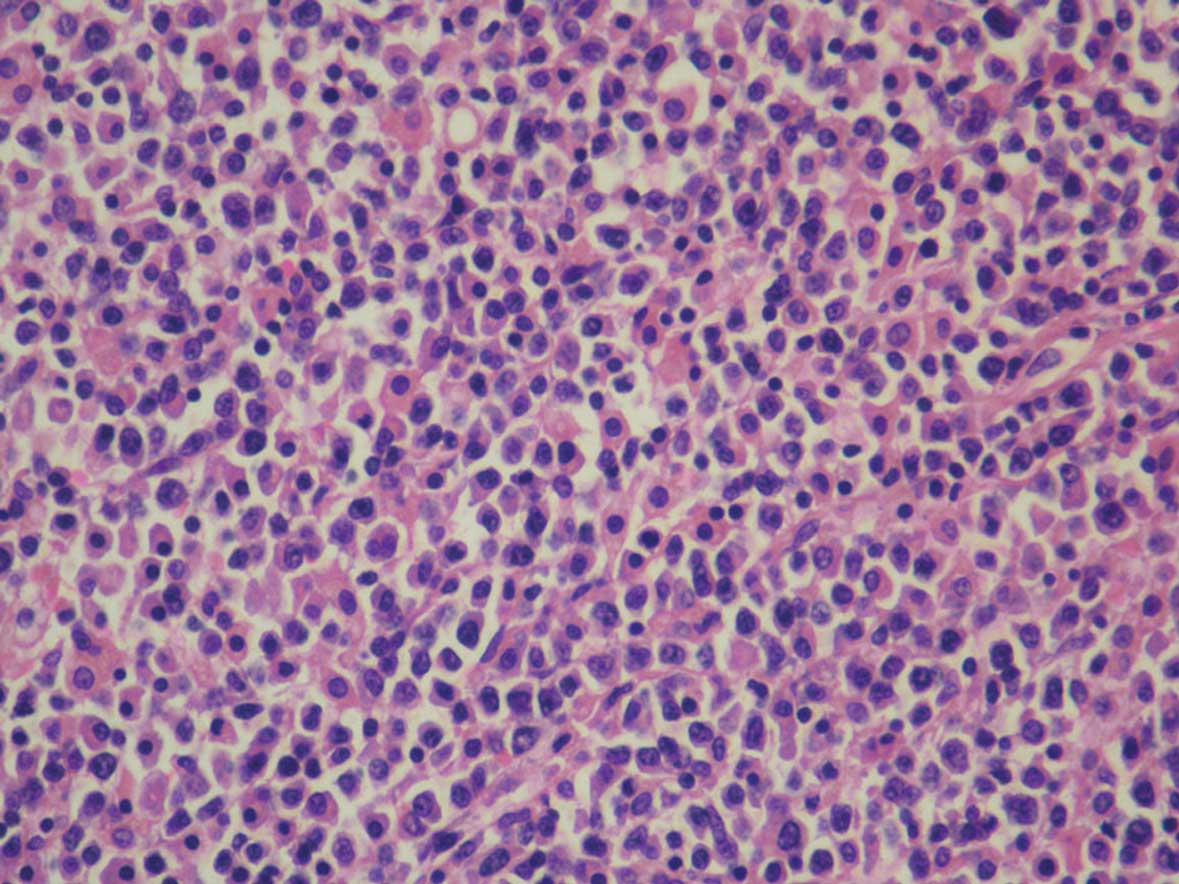

Гистохимические исследования: методы и результаты на изображениях

Раздел: Ключ к успеху